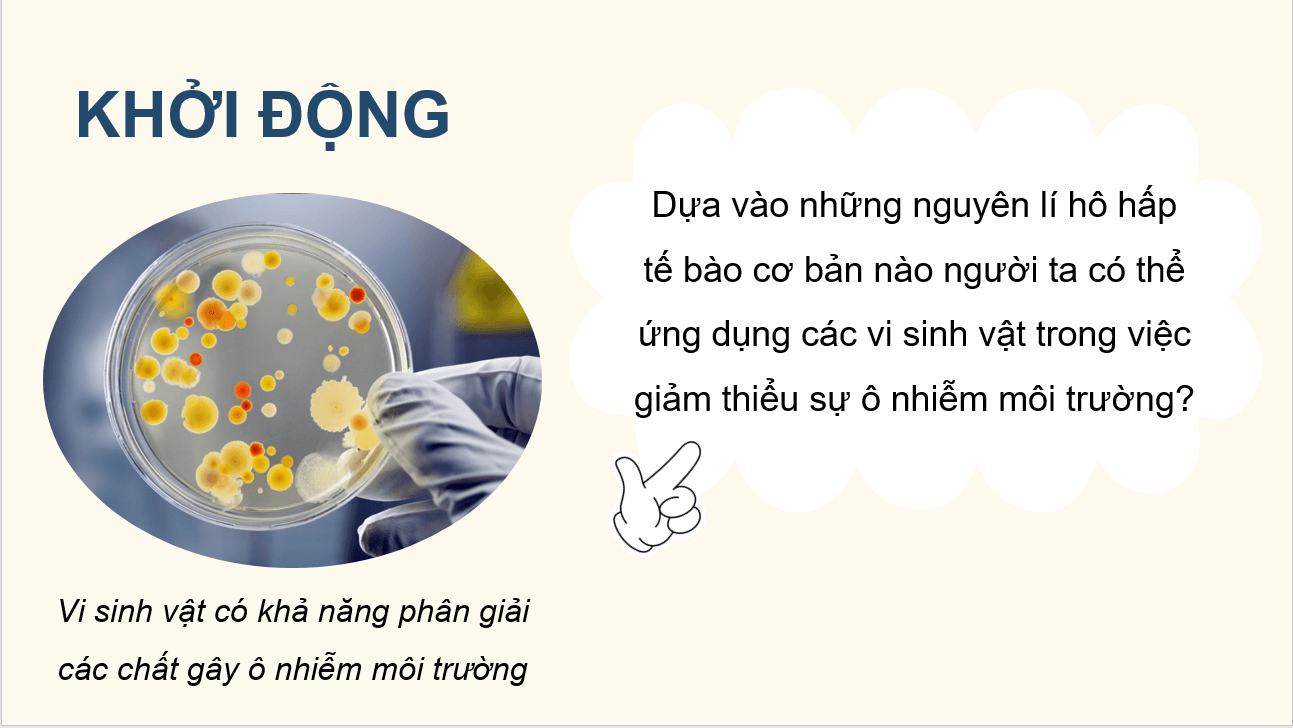
Giáo án điện tử Chuyên đề Sinh 10 Kết nối tri thức Giáo án điện tử Bài 10: Vi sinh vật trong phân giải các hợp chất làm ô nhiễm môi trường | PPT Chuyên đề Sinh học 10

Giáo án điện tử Chuyên đề Sinh 10 Kết nối tri thức Giáo án điện tử Bài 10: Vi sinh vật trong phân giải các hợp chất làm ô nhiễm môi trường
Với Giáo án điện tử Chuyên đề Sinh học 10 Kết nối tri thức Giáo án điện tử Bài 10: Vi sinh vật trong phân giải các hợp chất làm ô nhiễm môi trường hay nhất, thiết kế hiện đại, dễ dàng chỉnh sửa giúp Giáo viên có thêm tài liệu tham khảo để soạn bài giảng powerpoint Chuyên đề học tập Sinh 10.
Giáo án điện tử Chuyên đề Sinh 10 Kết nối tri thức Giáo án điện tử Bài 10: Vi sinh vật trong phân giải các hợp chất làm ô nhiễm môi trường
Chỉ từ 250k mua trọn bộ Kế hoạch bài dạy (KHBD) hay Giáo án điện tử Chuyên đề Sinh 10 Kết nối tri thức chuẩn kiến thức, trình bày đẹp mắt, dễ dàng chỉnh sửa:
- B1: gửi phí vào tk:
1133836868- CT TNHH DAU TU VA DV GD VIETJACK - Ngân hàng MB (QR) - B2: Nhắn tin tới Zalo VietJack Official - nhấn vào đây để thông báo và nhận giáo án
Bài giảng PPT Chuyên đề Sinh học 10 Giáo án điện tử Bài 10: Vi sinh vật trong phân giải các hợp chất làm ô nhiễm môi trường gồm 30 slide, với nội dung như sau:
................................
................................
................................
Trên đây tóm tắt một số nội dung miễn phí trong Kế hoạch bài dạy (KHBD) hay giáo án điện tử Chuyên đề Sinh học 10 Giáo án điện tử Bài 10: Vi sinh vật trong phân giải các hợp chất làm ô nhiễm môi trường sách Kết nối tri thức năm 2026 mới nhất, để mua tài liệu đầy đủ, Thầy/Cô vui lòng xem thử:
Xem thêm các bài soạn Giáo án điện tử Chuyên đề Sinh học lớp 10 Kết nối tri thức chuẩn khác:
Giáo án điện tử Chuyên đề Sinh 10 Bài 5: Khái quát về công nghệ enzyme
Giáo án điện tử Chuyên đề Sinh 10 Bài 6: Quy trình công nghệ sản xuất enzyme
Giáo án điện tử Chuyên đề Sinh 10 Bài 7: Ứng dụng của enzyme
Giáo án điện tử Chuyên đề Sinh 10 Bài 9: Vai trò của vi sinh vật trong xử lý ô nhiễm môi trường
Để học tốt lớp 10 các môn học sách mới:
- Giải bài tập Lớp 10 Kết nối tri thức
- Giải bài tập Lớp 10 Chân trời sáng tạo
- Giải bài tập Lớp 10 Cánh diều
Đã có app VietJack trên điện thoại, giải bài tập SGK, SBT Soạn văn, Văn mẫu, Thi online, Bài giảng....miễn phí. Tải ngay ứng dụng trên Android và iOS.
Theo dõi chúng tôi miễn phí trên mạng xã hội facebook và youtube:Nếu thấy hay, hãy động viên và chia sẻ nhé! Các bình luận không phù hợp với nội quy bình luận trang web sẽ bị cấm bình luận vĩnh viễn.
Đã có app VietJack trên điện thoại, giải bài tập SGK, SBT Soạn văn, Văn mẫu, Thi online, Bài giảng....miễn phí. Tải ngay ứng dụng trên Android và iOS.
Theo dõi chúng tôi miễn phí trên mạng xã hội facebook và youtube:Loạt bài Giáo án Sinh học 10 chuẩn nhất của chúng tôi được biên soạn bám sát nội dung sgk Sinh học 10 theo chuẩn Giáo án của Bộ GD & ĐT.
Nếu thấy hay, hãy động viên và chia sẻ nhé! Các bình luận không phù hợp với nội quy bình luận trang web sẽ bị cấm bình luận vĩnh viễn.
- Giáo án lớp 10 (các môn học)
- Giáo án điện tử lớp 10 (các môn học)
- Giáo án Ngữ văn 10
- Giáo án Toán 10
- Giáo án Tiếng Anh 10
- Giáo án Vật Lí 10
- Giáo án Hóa học 10
- Giáo án Sinh học 10
- Giáo án Lịch Sử 10
- Giáo án Địa Lí 10
- Giáo án Kinh tế Pháp luật 10
- Giáo án Tin học 10
- Giáo án Công nghệ 10
- Giáo án Giáo dục quốc phòng 10
- Giáo án Hoạt động trải nghiệm 10
- Đề thi lớp 10 (các môn học)
- Đề thi Ngữ Văn 10 (có đáp án)
- Chuyên đề Tiếng Việt lớp 10
- Đề cương ôn tập Văn 10
- Đề thi Toán 10 (có đáp án)
- Đề thi cương ôn tập Toán 10
- Đề thi Toán 10 cấu trúc mới (có đáp án)
- Đề thi Tiếng Anh 10 (có đáp án)
- Đề thi Vật Lí 10 (có đáp án)
- Đề thi Hóa học 10 (có đáp án)
- Đề thi Sinh học 10 (có đáp án)
- Đề thi Lịch Sử 10 (có đáp án)
- Đề thi Địa Lí 10 (có đáp án)
- Đề thi Kinh tế & Pháp luật 10 (có đáp án)
- Đề thi Tin học 10 (có đáp án)
- Đề thi Công nghệ 10 (có đáp án)
- Đề thi Giáo dục quốc phòng 10 (có đáp án)

Giải bài tập SGK & SBT
Giải bài tập SGK & SBT
 Tài liệu giáo viên
Tài liệu giáo viên
 Sách
Sách
 Khóa học
Khóa học
 Thi online
Thi online
 Hỏi đáp
Hỏi đáp

